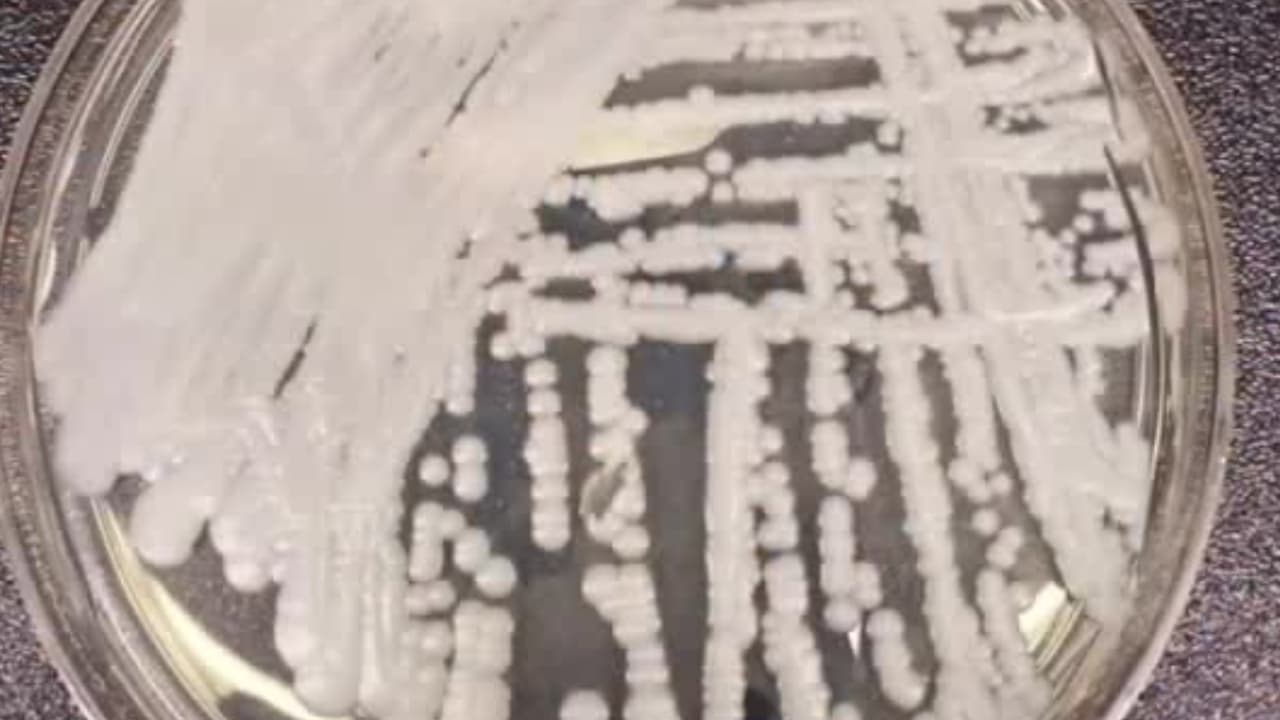
Un hongo mortal y resistente a medicamentos se propaga con rapidez en EEUU: hay 27 estados afectados

Se hacían pasar por directores de una funeraria y robaban el dinero del seguro de vida de los fallecidos
Dos personas fueron arrestadas por operar una funeraria sin licencia y falsificar información para robar los seguros de vida de los muertos. Las familias de los fallecidos temen que no les hayan entregado las cenizas correctas. Sigue las últimas noticias en Univision.
Por:Univision
Publicado el 28 ene 24 - 01:17 PM EST. Actualizado el 28 jun 24 - 10:33 AM EDT.